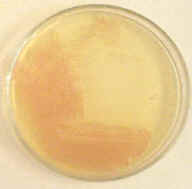
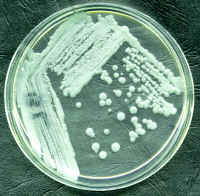

![]() |
Laboratory Investigations in Microbiology |
![]() |
E. coli K12 Enterobacter aerogenes Chromobacterium violaceum
E. coli B Neisseria subflava Micrococcus roseus
Pseudomonas aeruginosa Lactobacillus acidophilus Halobacterium salinarum
Corynebacterium pseudodiph. Edwardsiella tarda Staphylococcus saprophyticus
Alcaligenes faecalis Providencia alcalifaciens Klebsiella pneumoniae
Sporosarcina ureae
Sporosarcina ureae pigmentation Rhodospirillum rubrum

Serratia marcesens Serratia
marcesens pigmentation Serratia marcesens strain B



Staphylococcus aureus
Micrococcus luteus Vibrio
parahaemolyticus



Shigella
dysenteriae
Yersinia
enterocolitica
Bacillus
subtilis



Pseudomonas fluorescens
Staphylococcus epidermidis
Citrobacter freundii



Kurthia
Bacillus
cereus
Aeromonas hydrophila



Salmonella arizonae
Streptococcus lactis
Salmonella typhimurium



Clostridium sporogenes
Proteus vulgaris
Mycobacterium phlei



Pseudomonas putida
Enterococcus faecalis
Proteus mirabilis

Bacillus laterosporis
Bacillus mycoides
Azotobacter chroococcus |
Beige / brownish-green with age | |
| White / translucent |
|
|
| Beige / Cream - pink center in older colonies | ||
| White /
opaque |
||
Bacillus mycoides |
White / opaque - spreading, filamentous (rhizoid) | |
| Bacillus subtilis | White / opaque - large, flat, dull | |
Branhamella catarrhalis |
Beige / Cream |
|
| Purple opaque |
||
|
Beige / Cream |
|
|
| White translucent - spreading |
|
|
|
White
/ Beige |
||
| White / Beige - flat colonies | ||
|
Beige / Cream |
||
| White translucent |
|
|
|
Beige / Cream |
||
|
Beige / Cream |
||
|
Beige / Cream |
||
| Beige opaque |
||
| White translucent |
|
|
| Yellow opaque |
||
|
Pink opaque |
||
| White
opaque - dry & crumbly |
||
|
Beige / cream |
||
| Beige / Cream - swarming behavior |
|
|
|
Beige / Cream |
||
|
Beige / Cream |
||
| Beige
/ Pink center
(older) & diffusible blue-green pigment |
||
| White / beige |
||
| Yellow opaque |
|
|
|
Beige / Cream |
||
|
Beige / Cream |
||
|
Beige / Red |
||
| Serratia marcesens B | Red / orange - intense pigmentation | |
| White translucent |
|
|
|
White / Red |
||
| Yellow opaque |
||
|
Yellow-gold opaque |
||
|
White opaque |
||
|
White opaque |
||
|
White translucent |
||
|
Streptococcus pyogenes |
White translucent |
|
|
Veillonella parvula |
White
translucent |
|
| Beige / Cream |
||
| Yersinia enterocolitica | Beige / Cream |
© 2003 - 2015 José de Ondarza, Ph.D.